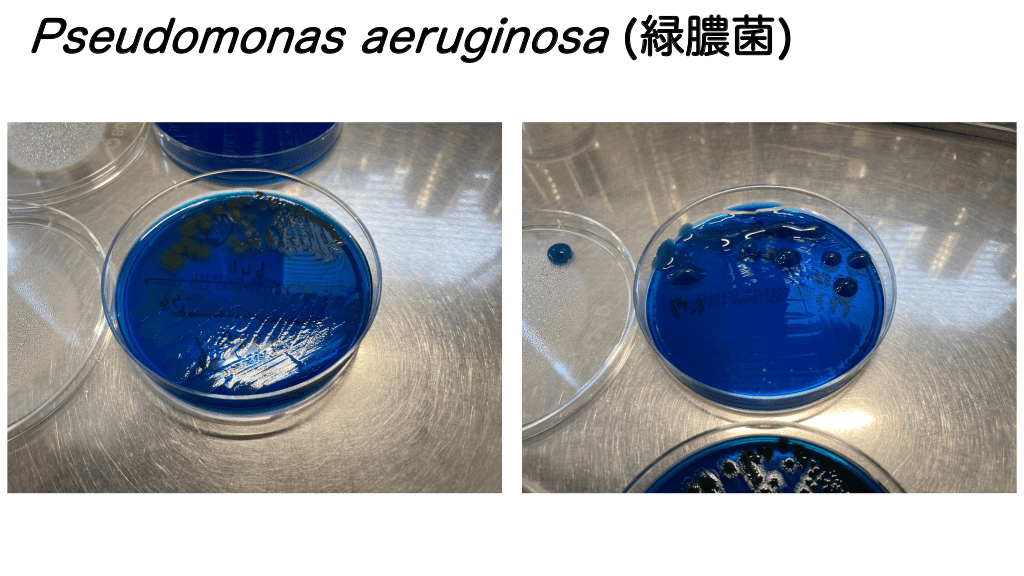

1/24
関連するスライド
血液腫瘍と感染症
森本将矢
135988
310
【2021年上半期まとめ】ER(救急外来)診療に役立つ最新の医学書5選
三谷雄己
73796
109
冠動脈造影の見方とやり方
うし先生
43813
204
Drゆみの Weekly Journal Scan vol.3
医療法人社団ゆみの
1686
2
ミニマム緑膿菌
高野哲史
Award 2020 受賞者
医療法人社団東光会戸田中央総合病院
55,609
175
概要
ミニマムシリーズ第一弾です。こうやってすぐシリーズとか題して完遂できずに挫折するのが得意です。
このスライドでは緑膿菌に代表されるブドウ糖非発酵菌のグループ(僕たちは「PASグループ」と呼んでいます)についてミニマムに必要な知識をまとめています。
スライドの中で更なる解説が必要な点やご不明な点については、お気軽にフォームよりお寄せ下さい。本説明欄でお答えします。
本スライドの対象者
医学生/研修医/専攻医
投稿された先生へ質問や勉強になったポイントをコメントしてみましょう!
0 件のコメント
高野哲史さんの他の投稿スライド
感染症診療のマテリアル
高野哲史
205,828
886
"代替薬時代"の感染症外来
高野哲史
87,167
207
抗真菌薬 - 総論と薬剤各論,侵襲性カンジダ症を中心としたメジャーな真菌症 -
高野哲史
72,712
282
このスライドと同じ診療科のスライド
テキスト全文
ミニマム緑膿菌とグラム陰性桿菌の分類
#1.
ミニマム緑膿菌 を中心としたブドウ糖非発酵菌
#2.
グラム陰性桿菌のグルーピング “PEK” “PMSECK” “PAS”
#3.
グラム陰性桿菌のグルーピング “PEK” Proteus mirabilis, Escherichia coli, Klebsiella pneumoniae “PMSECK” Providencia sp., Morganella morganii, Serratia marcescens, Enterobacter cloacae, Citrobacter freundii, Klebsiella aerogenes “PAS” Pseudomonas aeruginosa, Acinetobacter baumannii, Stenotrophomonas maltophilia
#4.
グラム陰性桿菌のグルーピング “PEK” Proteus mirabilis, Escherichia coli, Klebsiella pneumoniae “PMSECK” 今日はこれ Providencia sp., Morganella morganii, Serratia marcescens, Enterobacter cloacae, Citrobacter freundii, Klebsiella aerogenes “PAS” Pseudomonas aeruginosa, Acinetobacter baumannii, Stenotrophomonas maltophilia
#5.
グラム陰性桿菌のグルーピング “PEK” Proteus mirabilis, Escherichia coli, Klebsiella pneumoniae “PMSECK” Providencia sp., Morganella morganii, Serratia marcescens, Enterobacter cloacae, Citrobacter freundii, Klebsiella aerogenes “PAS” 特にこれ Pseudomonas aeruginosa, Acinetobacter baumannii, Stenotrophomonas maltophilia
Pseudomonas aeruginosaの細菌学的特徴と臨床像
#6.
Pseudomonas aeruginosa (緑膿菌) [細菌学的特徴] * 偏性好気性のブドウ糖⾮発酵菌 - 原則,好気環境でしか発育しない → つまり⾎液培養は︖ * 健常⼈での保菌は極めて珍しい = 正常細菌叢ではない - 免疫障害やデバイス,院内での獲得 - バイオフィルムを形成し難治性感染症の原因となる → 特に⽔周りを好む * あまりに多彩過ぎる薬剤耐性メカニズム - 内因性 = ⽣まれながらに持つ豊富な耐性機序 - 外因性 = プラスミドなどで伝播し獲得される耐性機序 - 腸内細菌⽬細菌と緑膿菌を明確に区別しなければならない所以
#7.
Pseudomonas aeruginosa (緑膿菌)
#8.
Pseudomonas aeruginosa (緑膿菌)
#9.
Pseudomonas aeruginosa (緑膿菌) [臨床像] * 基本的には院内・免疫不全者の感染症の原因微⽣物 - ひと⼝にいうと“弱毒菌”のはずである - 治療も⼀般的なグラム陰性桿菌より⾯倒臭い(とても) → 治療中の耐性化が頻繁に経験される → そんな環境で⽣まれた⽤語“緑膿菌カバー”の功罪 - 軽微な⽪膚感染症(外⽿道炎や⽑嚢炎のような)は免疫健常者でも起こるようだ * 全⾝どこでも感染を成⽴させる - ⾎流感染症の原因は肺炎・尿路・⽪膚軟部組織と続く - 発熱性好中球減少症の原因として最重要︕落としてはならない - バイオフィルムを形成し難治性感染症の原因となる → 特に⽔周りを好む
Pseudomonas aeruginosaの治療法と耐性メカニズム
#10.
Pseudomonas aeruginosa (緑膿菌) [治療] 抗緑膿菌作用のある抗菌薬? 最低6つ
#11.
Pseudomonas aeruginosa (緑膿菌) [治療] * “緑膿菌カバー”のある抗菌薬 抗緑膿菌ペニシリン: ピペラシリン 抗緑膿菌セファロスポリン: セフォペラゾン,セフタジジム,セフェピム 新世代セファロスポリン: セフトロザン モノバクタム: アズトレオナム カルバペネムの⼀部: イミペネム,メロぺネムなど アミノグリコシド: アミカシン,トブラマイシン,ゲンタマイシンなど フルオロキノロン: シプロフロキサシン,レボフロキサシン ポリミキシン: コリスチン
#12.
Pseudomonas aeruginosa (緑膿菌) [治療] * “緑膿菌カバー”のある抗菌薬 経験的治療: タゾバクタム・ピペラシリン, セフェピム,メロぺネム 標的治療: ピペラシリン,セフタジジム 耐性緑膿菌治療: タゾバクタム・セフトロザン,アズトレオナム, アミノグリコシド,フルオロキノロン, カルバペネム,コリスチン ポジション不明瞭: セフォペラゾン
#13.
Pseudomonas aeruginosa (緑膿菌) (続け) 基本 [治療] * “緑膿菌カバー”のある抗菌薬 経験的治療: タゾバクタム・ピペラシリン, セフェピム,メロぺネム 標的治療: ピペラシリン,セフタジジム 使いたくない 耐性緑膿菌治療: タゾバクタム・セフトロザン,アズトレオナム, アミノグリコシド,フルオロキノロン, カルバペネム,コリスチン ポジション不明瞭: セフォペラゾン
#14.
Pseudomonas aeruginosa (緑膿菌) [治療] * “緑膿菌カバー”のある抗菌薬を整理せよ︕ = ⼿持ちの抗菌薬を掌握する ア ン チ バ イ オ グ ラ ム * ローカルファクターを把握せよ︕ = 敵(緑膿菌)を知る
Pseudomonas aeruginosaの薬剤耐性の詳細
#15.
Pseudomonas aeruginosa (緑膿菌) [治療] * 基本,単剤治療 - ただし,まだ併⽤療法の有益性がなくなったと決まった訳ではない - 特に難治症例や薬剤耐性緑膿菌(後述)では併⽤療法は,アリ * 臓器 – 微⽣物 – 抗菌薬の三位⼀体 - 臓器移⾏性がなければ治療はできない(eg. アミノグリコシド) - 感受性がなければ治療はできない - 薬剤投与量が不⼗分ならば治療はできない
#16.
Pseudomonas aeruginosa (緑膿菌) [薬剤耐性] * Multidrug-Resistance P. aeruginosa; MDR-P <<下記5クラスの抗菌薬で少なくとも3クラス、各クラス1つに耐性>> ・ペニシリン ・セファロスポリン ・カルバペネム ・フルオロキノロン ・アミノグリコシド (本邦ではシプロフロキサシン・イミペネム・アミカシンに耐性の場合は5類感染症として届出) * difficult-to-treat Resistance P. aeruginosa; DTR-P <<以下の抗菌薬全てに耐性>> タゾバクタム・ピペラシリン セフタジジム セフェピム アズトレオナム メロぺネム イミペネム シプロフロキサシン レボフロキサシン
#17.
Pseudomonas aeruginosa (緑膿菌) [薬剤耐性] * 感受性があればカルバペネム以外のβ-ラクタムで治療する - この期に及んでもカルバペネムはスペアされるべき - カルバペネムは他のβ-ラクタムより耐性を取られやすい (セフタジジム,ピペラシリン・タゾバクタム) - 時に⼤量投与(専⾨家へ相談),点滴時間延⻑ - 新規β-ラクタムも已むを得ない,が,ホイホイ使わないこと → タゾバクタム・セフトロザン(ザバクサ®),cefiderocolなど * 抗菌薬の併⽤により感受性が回復するかもしれない - BCプレートʻ栄研ʼ® - なるべく既存の抗菌薬を活⽤する
Acinetobacter baumanniiの特徴と治療法
#18.
Acinetobacter baumannii [要点] * “グラム陰性菌界の⻩⾊ブドウ球菌” - 丈夫で乾燥に強い.環境中や医療器具表⾯でしばらく⽣存(6⽇くらい) → ⼈⼯呼吸器,⾎管内カテーテル,PCのキーボードなど要注意 → 時に消毒薬にも抵抗性を⽰す - 全⾝どこでも感染症を成⽴させ得る → ⾎流感染症,⼈⼯呼吸器関連肺炎(VAP),褥瘡感染,など → ⾎液培養陽性例は必ず⾎液培養の陰性化を確認すること︕ * 死亡率が⾼い - 本菌種が感染症を起こす患者は⼤概衰弱していることも⼿伝う
#19.
Acinetobacter baumannii [要点] * 薬剤耐性傾向が強い - 内因性/外因性の耐性獲得 = 緑膿菌と類似 - カルバペネム耐性=pan-β-ラクタム耐性となりがちでタチが悪い → カルバペネマーゼ(OXA型がメジャー)産⽣株も ・ 更にメタロ-β-ラクタマーゼ産⽣株(NDM型)も地域により報告あり → 特殊な抗菌薬を持ち出さざるを得ない(タイゲサイクリン,コリスチンなど) - 幸い,まだ⽇本には多剤耐性A. baumannii(MDR-A)はとても稀 → 輸⼊症例に要注意 → シプロフロキサシン,イミペネム,アミカシン耐性なら届出
#20.
Acinetobacter baumannii [治療] * 恐らく最も信頼できるのはスルバクタム - スルバクタム単剤は上市されていない - 法外な量を使⽤する推奨もあるが,専⾨家へ相談 - 耐性も存外,稀 * スルバクタムがダメなら,カルバペネムも已む無し - 少なくとも本邦においてはスルバクタム耐性の⽅が稀 * MDR-Aについてはケースバイケース
Stenotrophomonas maltophiliaとその他の重要な病原菌
#21.
Stenotrophomonas maltophilia [要点] * 染⾊体性にカルバペネマーゼを産⽣ - 故に,どうあがいてもカルバペネム耐性 → 翻って,カルバペネム系抗菌薬の使⽤が発症のリスク * 呼吸器感染症と⾎流感染症にご⽤⼼ - ⾎流感染症より呼吸器感染症の⽅が難治 → 意外にも肺炎(出⾎性肺炎)の⽅が死亡率が⾼い * 治療もトリッキー - ファーストラインはST合剤,ただ選択しにくいことも多い - セカンドラインはミノサイクリン,レボフロキサシン
#22.
そのほか * Burkholderia mallei / pseudomallei - ⿐疽(glanders) / 類⿐疽(melioidosis)の原因菌 → 要届出 いずれも輸⼊感染症として重要.海外渡航歴に留意 後者はDMや慢性肺疾患,慢性腎疾患,サラセミア等がリスク セフタジジムやカルバペネムで初期治療,ST合剤で維持期治療 検査室での暴露を防ぐため,疑う場合は必ず連絡すること︕ * Burkholderia cepacia - 嚢胞性線維症患者の呼吸器感染症(壊死性肺炎)で重要 - ST合剤,カルバペネム,ミノサイクリンで治療 * Elizabethkingia meningoseptica - 未熟児の髄膜炎や免疫不全者の呼吸器・⾎流感染症 - ST合剤,キノロン,ミノサイクリンなどを単独/併⽤ - 珍しく,バンコマイシンが効く(かもしれない)グラム陰性桿菌
まとめと御清聴の御礼
#23.